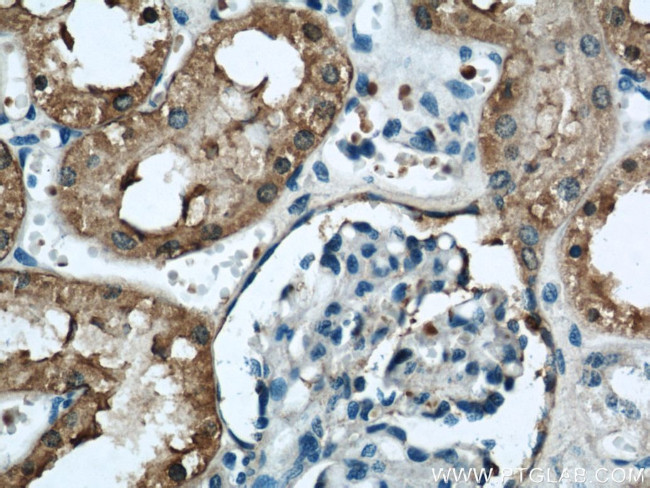
FTCD Antibody in Immunohistochemistry (Paraffin) (IHC (P))

Search
Proteintech
FTCD Polyclonal Antibody
{{$productOrderCtrl.translations['antibody.pdp.commerceCard.promotion.promotions']}}
{{$productOrderCtrl.translations['antibody.pdp.commerceCard.promotion.viewpromo']}}
{{$productOrderCtrl.translations['antibody.pdp.commerceCard.promotion.promocode']}}: {{promo.promoCode}} {{promo.promoTitle}} {{promo.promoDescription}}. {{$productOrderCtrl.translations['antibody.pdp.commerceCard.promotion.learnmore']}}







Please note: We are reviewing Western blot images included in the antibody testing data in our catalog, including those provided by third parties. Unless expressly labeled or annotated as “raw-unedited”, Western blot images included in the antibody testing data in our catalog may have been edited, optimized or otherwise adjusted for presentation.
产品信息
21959-1-AP
种属反应
已发表种属
宿主/亚型
分类
类型
抗原
偶联物
形式
浓度
规格
纯化类型
保存液
内含物
保存条件
运输条件
产品详细信息
Immunogen sequence: TKEQAHRIA LNLREQGRGK DQPGRLKKVQ GIGWYLDEKN LAQVSTNLLD FEVTALHTVY EETCREAQEL SLPVVGSQLV GLVPLKALLD AAAFYCEKEN LFILEEEQRI RLVVSRLGLD SLCPFSPKER IIEYLVPERG PERGLGSKSL RAFVGEVGAR SAAPGGGSVA AAAAAMGAAL GSMVGLMTYG RRQFQSLDTT MRRLIPPFRE ASAKLTTLVD ADAEAFTAYL EAMRLPKNTP EEKDRRTAAL QEGLRRAVSV PLTLAETVAS LWPALQELAR CGNLACRSDL QVAAKALEMG VFGAYFNVLI NLRDITDEAF KDQIHHRVSS LLQEAKTQAA LVLDCLETRQ E (192-541 aa encoded by BC136395)
靶标信息
Golgi Protein, 58K is a bifunctional enzyme that channels 1-carbon units from formiminoglutamate, a metabolite of the histidine degradation pathway, to the folate pool. Mutations in this gene are associated with glutamate formiminotransferase deficiency. Alternatively spliced transcript variants have been found for this gene.
仅用于科研。不用于诊断过程。未经明确授权不得转售。
生物信息学
蛋白别名: 58 kDa microtubule-binding protein; Formimidoyltransferase-cyclodeaminase; formiminotransferase cyclodeaminase; Formiminotransferase-cyclodeaminase; FTCD; glutamate formiminotransferase; LCHC1
基因别名: FTCD
UniProt ID: (Mouse) Q91XD4, (Rat) O88618
Entrez Gene ID: (Mouse) 14317, (Rat) 89833